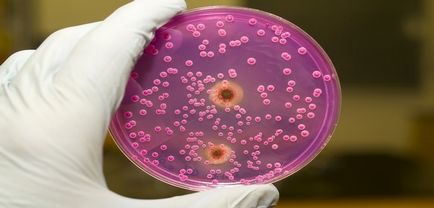

Az első jelei a torokgyulladás felnőttek, gyermekek, mi a teendő, ha az első tünetek
Angina nevezzük akut fertőző betegsége, amely hatással van a szövetekben a mandulák. Annak ellenére, hogy a betegség elterjedt a lakosság körében, elég gyakran összetévesztik a könnyebb típusú betegség. Ez akkor fordul elő elsősorban annak a ténynek köszönhető, hogy a legtöbb ember nem tudja megkülönböztetni az első jelei a torokfájás torokgyulladás tüneteit. stomatitis vagy gégegyulladás.
Önmagában a torokfájás nagyon veszélyes betegség. Helytelen kezelés vagy önálló a betegség kezelésében vezethet súlyos szövődmények, ami viszont, negatív hatással az ilyen létfontosságú szerveket, mint a szív, a máj, a vese, a csont. Ezért képes felismerni az első jelei a torokfájás egy gyermek vagy egy felnőtt, és megteszi a megfelelő lépéseket, hogy foglalkoznak velük, elengedhetetlen mindenki számára.
Az első tünetek angina kissé eltérhet attól függően, hogy a fajta a betegség. betegség elválasztás történik típusokba okokon alapuló váltott meg.
okai
Az ok az ilyen betegségek például az angina, fekszik a növekedés az emberi test, az úgynevezett, a kórokozó mikroorganizmusok. Számos szervezetek bejutását az emberi test, amely bizonyos körülmények között, az alapja a megjelenése a betegség. A lista tartalmazza:
- vírusok;
- Candida gomba típusok;
- baktériumok (a legtöbb esetben, hemolitikus streptococcus baktérium).
Tény, hogy a három fő forrását betegség eredete a felosztás típusú angina. Összesen három fő típusa van: a vírusos, gombás és bakteriális.
Kapcsolat a kórokozó az emberi szervezetben fordul elő a hagyományos típusú fertőző betegségek által a levegőben lebegő cseppek vagy a táplálék által érintkezik a hordozóval kór. Azonban a penetráció a fertőzés mandula szövetből nem elég.
Sőt, néhány baktériumfaj, gyakran megtalálható a szövetekben a mandulák és a felső légutak, hosszú ideig, és ez nem mindig vezet a betegség. Ha a stabil működése az immunrendszert, és egy normál sebességgel védő reakció a szervezet, a baktériumok elpusztulnak érintkezik egy másik felülete a mandulában és a felső légúti traktusban.
A lényeg az, hogy az újjászületés baktériumok (vírusok, gombák) angina kell a megfelelő feltételeket. Ezért számos tényező befolyásolja a fejlődését a betegség: a legyengült immunrendszer, magas stressz, a korábbi fertőzések vagy jelenléte krónikus és rossz szokások.
Az első tünetek angina

Az angina akut megnyilvánulásai a betegség, az úgynevezett mandulagyulladás. A természeténél fogva a betegség, azt mondja, hogy a betegség tünetei eltérnek az élességet és kényelmetlenséget a páciens számára. Az első tünetek a betegség, például az angina közé tartoznak:
- növelése és a tapintásra való fájdalomnak, a nyaki nyirokcsomók;
- gyulladás és bőrpír a mandulák;
- éles, kemény tolerálható nyelési fájdalom a torokban;
- gyors és jelentős hőmérséklet-emelkedés;
- hirtelen fejfájás;
- hidegrázás;
- fáradtság és általános gyengeség, a test.
Ezen kívül a fenti tünetek is vannak közvetett jelei a betegség, az úgynevezett angina. Ezek közé tartozik: hasi fájdalom, széklet rendellenesség (hasmenés), hányinger, hányás és szédülés. Előfordul, hogy néha, indirekt jelek előfordulhat néhány nappal a többit. Ezért, amikor a oktalan hányinger, folytatjuk egy pár napig, meg kell átesnie.
Emellett van számos egyedi jellemzőit egy bizonyos típusú angina. Például, a fejlesztés során a test gennyes (bakteriális), mandulagyulladás, tonsilla felületű sebek tele fehér gennyes tömegeket. Annak jelzése, hogy milyen típusú vírusos betegség hiánya hőmérséklet-ingadozások. És a megfigyelés a gombás betegség kialakított típusú tejes plakk, amely tudja mozgatni, és nyálkahártya szövetek a száj felületén a mandulák.
Mi a teendő, ha mutatkozni torokfájás? Az első helyen -, hogy egy orvos. Minél korábban betegséget észlel, a gyorsabb és könnyebb lesz, hogy adja át a gyógyulási folyamatot.
Self figyelmen kívül hagyja vagy betegség, ebben az esetben csak akkor vezet a szövődmények.
Még a megnyilvánulása néhány ilyen tüneteket, fellebbezést a szakember nem halasztható a végtelenségig. Akut mandulagyulladás formájában előrehaladott szakaszában, vagy a fejlesztés a komplikációk, ez magában foglalja a sokkal részletesebb listát a kezelések és gyógyszerek, nem beszélve a kezelés időtartama, amely hajtjuk végre egy álló megfigyelés.
Ebben a tekintetben, hogy bölcs dolog figyelmen kívül hagyni az első jelei a megfázás és a gyermekek és a felnőttek. Van-e olyan töltött nap lábuk alatt egy hosszú kúra a betegség? Alig.